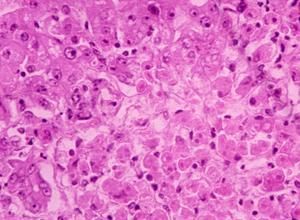
藥物肝損害

定義
例如有些以前被認為對易感者是過敏原的藥物,卻能通過其毒性中間產物直接損傷細胞膜.
目前,藥物性肝損害的分類並不完全令人滿意,但大多數急性病例仍可分為肝細胞型,膽汁淤積型(有或無炎症)和混合型.有些藥物能引起包括腫瘤在內的慢性肝損害.藥物誘導的溶血可引起非結合性高膽紅素血症而發生輕度黃疸,但無真正的肝損傷,因而肝功能試驗正常.
肝細胞壞死
在概念上可分為直接細胞毒性和特異反應性,但這種分類是人為的.
直接細胞毒性 大多數具有直接肝毒性的藥物能導致劑量相關性肝壞死,並且對其他臟器(如腎臟)也有損害.這些藥物引起的肝臟損害有幾種,例如四氯化碳及有關碳氫化合物引起肝腺泡3區(小葉中央區)壞死和脂肪浸潤;磷主要引起肝腺泡1區(門脈周圍)壞死;攝入各種捕蠅屬蘑菇導致致命性的肝出血性壞死;大劑量靜脈注射四環素,特別在妊娠婦女可引起肝臟瀰漫性脂肪小滴浸潤,且臨床表現類似肝炎.
急性過量服用非麻醉止痛劑撲熱息痛是暴發性肝功能衰竭的重要病因(參見第263節撲熱息痛中毒).成人撲熱息痛劑量>10~15g或>4g/d持續服用數天就可使肝臟內谷胱苷肽耗竭.在正常情況下,谷胱苷肽通過與可能有毒性的中間代謝產物結合而使其解毒.如果這種作用被飽和,游離中間代謝產物就可與肝內大分子結合,從而產生主要位於肝腺泡3區的肝壞死.微血管損傷顯然是一個重要的早期肝損害機制.
肝臟損害常在攝入撲熱息痛後2~5天明顯,這時也出現了急性肝細胞壞死的臨床和生化證據.攝入撲熱息痛劑量>25g,中毒後的死亡率急劇升高;由於乙醇誘導P-450酶後增加了毒性中間代謝產物的形成,從而導致營養性谷胱苷肽耗竭,所以很低的劑量就可使酗酒者死亡.乙醯半胱氨酸能補充谷胱苷肽,可防止肝壞死,如在中毒後10~12小時內套用可挽救患者生命;延遲至16~20小時則療效很差.乙醯半胱氨酸沒有毒性,可經口服和靜脈注射給藥,口服劑量為首次140mg/kg,然後70mg/kg,每4小時一次,連續3天.靜脈注射劑量為300mg/kg,維持輸注20小時,其中一半劑量需在15分鐘內注射完畢.有證據表明,撲熱息痛尚可引起慢性肝損害.
特異反應性
藥物可引起在臨床,生化以及組織學方面類似於病毒性肝炎的急性肝細胞壞死.這種肝細胞壞死與上述中毒性壞死不同,一般被認為是特異體質性的,但是其機制不明,並可能因藥而異.可引起特異體質肝損害的藥物很多,包括異煙肼,甲基多巴,單胺氧化酶抑制劑,消炎痛,丙基硫氧嘧啶,苯妥英鈉及麻醉劑氟烷.其中研究得最透徹的是異煙肼和氟烷.
異煙肼可引起20%的患者輕度而短暫的轉氨酶增高,1%~2%的患者可發生症狀明顯的肝炎,並可能是致死性的.年齡超過30歲和那些合用利福平的患者似乎更易感.雖然慢性乙醯化個體發生肝細胞毒性的可能性明顯增加,但乙醯化狀態的作用尚有爭議.異煙肼引起的肝損傷不像大多數其他藥物性肝炎在服藥幾周內即可起病,而可能在服藥後一年才發病,此時往往會忽略與異煙肼的聯繫.如不停藥,可發展為慢性肝炎和肝硬化.異煙肼引起的肝損害是由於過敏反應還是肝毒性產物的作用目前尚不明確,但大多數證據傾向於後者.
氟烷相關性肝炎較為罕見,多發生於短時間內多次接受氟烷麻醉的患者.氟烷麻醉術後不明原因的發熱是一個警告信號.目前,氟烷引起肝損害的機制尚不清楚,可能與中間代謝產物的毒性作用,細胞缺氧,脂質過氧化及免疫功能紊亂有關.肥胖是一個危險因素,因為氟烷的代謝產物可貯存於脂肪組織.在典型病例,嚴重的肝炎可發生於術後幾天或幾周,常以發熱作為預示.氟烷相關性肝炎的潛伏期較短,肝炎病毒B和C血清標誌物陰性,偶有嗜酸性粒細胞增多或皮疹,有時在組織學方面也存在細微的差異,這些都有助於和輸血後肝炎鑑別.這種肝炎的死亡率很高,但存活者往往能痊癒.與氟烷同類的麻醉劑甲氧氟烷和氟甲氧氟烷也可引起這種綜合徵.
膽汁淤積
很多藥物能引起原發性膽汁淤積反應.其機制常不清楚,但臨床上膽汁淤積至少可分為吩噻嗪型和類固醇型兩種類型.吩噻嗪型膽汁淤積是一種門脈周圍的炎症反應,往往起病急,發熱,轉氨酶和鹼性磷酸酶水平升高.這種膽汁淤積很難與肝外膽道阻塞鑑別,甚至通過肝活檢也難以區別.這種反應可能是由個體特異體質所決定的,因此在有些病例出現嗜酸性細胞增多和其他過敏反應的表現.但是,另一些證據表明,這種反應是藥物干擾膜ATP酶活性而對肝內小膽管產生直接毒性作用所致.服用氯丙嗪的患者中大約有1%發生這種類型的膽汁淤積,而服用其他吩噻嗪類藥物的患者則很少發生這種肝損害.停用藥物後,患者通常可以完全恢復,但極少患者即使停藥,也可發展為慢性膽汁性肝硬化.三環類抗抑鬱藥,氯磺丙脲,保泰松及無味紅黴素等其他藥物也可引起類似的病變,但尚未明確這些藥物是否會發展為慢性肝病.
類固醇型膽汁淤積是一種只有很輕微或沒有肝細胞炎症反應的單純型膽汁淤積反應.通常起病緩慢,沒有全身症狀.鹼性磷酸酶升高,而轉氨酶改變不明顯.肝活檢僅提示中央區域膽汁淤積,而很少有門脈反應或肝細胞紊亂.停用藥物後,患者可痊癒.此類膽汁淤積可因口服避孕藥,甲基睪丸酮及相關藥物而引起,這些藥物大多C-17位烷基化的類固醇激素.大約有1%~2%口服避孕藥婦女發生這種綜合徵.可能由於遺傳因素的不同,這種綜合徵在各國的發病率高低不一.這種藥物反應可能是由於性激素促進膽汁形成的生理反應過強所致,而不是免疫性過敏反應或膜毒性作用.雖然這些藥物引起膽汁運輸功能障礙的確切機制尚不明確,但它們嚴重影響膽小管內的液體流動及纖毛運動.
類固醇型膽汁淤積與妊娠性膽汁淤積密切相關.患過妊娠性膽汁淤積的婦女口服避孕藥時常發生藥物性膽汁淤積,同樣,口服避孕藥而藥物性膽汁淤積的婦女也容易發生妊娠性膽汁淤積.
混合性反應
有些藥物可以引起肉芽腫或其他難以歸類的肝損害,即混合型肝功能障礙.這類藥物包括氨基水楊酸,磺胺,某些抗生素,奎尼丁,別嘌呤醇,丙戊酸和阿司匹林等.洛伐他汀和相關的膽固醇調節藥物引起的亞臨床型轉氨酶升高並非罕見,但嚴重的肝損傷少見.很多抗腫瘤藥也能引起這種肝損傷,其機制因藥而異.
慢性肝病
異煙肼,甲基多巴,呋喃坦啶等引起的進行性肝損害與慢性肝炎難以鑑別.有些患者以急性肝炎起病,另一些則隱匿發病,最終可發展成為肝硬化.據報導,長期服用撲熱息痛每日劑量低於3g的患者可出現慢性肝炎並伴有肝纖維化的表現.酗酒者特別易感,酗酒者如出現很高的轉氨酶水平,特別是AST(在單純性酒精性肝炎中很少超過300IU),應懷疑本病的存在.心臟病用藥胺碘酮(amiodarone)偶爾也可引起慢性肝損傷,其組織學改變類似酒精性肝病,包括Mallory小體的存在;膜磷脂沉積是發病機制之一.
如上所述,氯丙嗪很少引起伴有膽道纖維化的慢性膽汁淤積.經肝動脈灌注化療藥物(尤其是氟尿苷)可引起類似硬化性膽管炎樣病變;長期服用甲氨蝶呤(通常用於治療牛皮癬或類風濕性關節炎)可隱匿地引起進行性肝纖維化,肝功能試驗一般無明顯改變,需作肝活檢才能確診.儘管臨床上甲氨蝶呤引起的肝纖維化並不常見,但是如果其累計用量已達1.5~2g,大多數作者推薦定期作肝活檢.砷劑可引起非硬化的肝纖維化和門脈高壓,而且大量服用維生素A或煙酸的健康嗜好者偶爾也會發生慢性肝纖維化.在許多熱帶和亞熱帶國家,食用含有黃麴黴毒素的霉變食物可能是引起慢性肝病和肝細胞癌的重要原因.
相當多的證據表明,口服避孕藥除了引起上述的膽汁淤積外,還偶可引起良性肝腺瘤,引起肝細胞癌者罕見(參見第47節原發性肝癌).此外,口服避孕藥還可使肝內局灶性結節樣增生病變(腺瘤樣錯構瘤性病變)增大,但此相關性並不能說明其是致病因素.腺瘤和局灶性結節樣增生往往沒有臨床表現,但可表現為突然腹腔內破裂和出血,需緊急腹腔探查.口服避孕藥還有引起全身性的高凝血傾向,口服避孕藥的婦女常可發生肝靜脈血栓形成,引起Budd-Chiari綜合徵.此外,這些藥物還能促進膽石形成,增加膽道結石的發病率.
對肝有或可能損害的藥物
1,全身麻醉藥 氟烷 氯仿 安氟醚 甲氧氟烷 三氯乙烯 三氟乙基乙烯醚 二乙烯醚等可損害肝細胞。
2,抗癲癇藥 三甲雙酮 丙酸 卡馬西平 苯妥英 苯巴比妥可引起肝細胞-毛細膽管型或混合型損害。
3,抗精神病藥 氯丙嗪 甲哌氯丙嗪及其他吩嗪類藥物和氯哌啶醇 環類抗抑鬱藥阿米替林。
4,解熱鎮痛藥 水楊酸類 布洛芬 消炎痛 別嘌呤醇 保松 金製劑等可引起轉氨酶升高。
5,骨胳肌鬆弛藥 硝苯海呋因 氯苯唑中致膽汁閼積。
6,類固醇類 同化類固醇 避孕類固醇可致膽汁閼積。
7,口服降糖藥 醋磺已脲 甲磺丁脲等磺脲類可引起肝細胞型損害。
8,抗甲狀腺藥 甲亢平 他巴唑 甲基硫氧嘧啶 硫尿嘧啶可引起肝細胞-毛細膽管型損害,丙基硫氧嘧啶可致肝細胞損害。
9,抗微生物藥 氨苄青黴素 羥氨苄青黴素 羥苄青黴素 克林黴素 利福平 異煙肼可引起肝細胞型損害;氯黴素 磺胺類 硝酸呋類 對氨基水楊酸類 灰黃黴素可引起肝細胞-毛型或肝細胞型損害;四環素可引起脂肪壞死;紅黴素 無味紅黴素和三乙醯竹桃黴素可引起肝細胞-毛細膽管型損害。二性黴素B可引起變態反應性肝炎伴肝脂肪變性。
10,心血管藥 緩脈靈 苯茚二酮(抗凝血藥) 氯酮(利尿藥) 嗪類利尿藥 甲基多巴 速尿 普魯卡因醯胺 奎尼丁 安妥明 安吉林可引起肝功異常。
11,抗癌藥 左鏇門冬醯胺酶 氮胞苷 重氮絲氨酸 甲苄肼 爭光黴素 氨甲蝶呤 絲裂黴素 光輝黴素 6-巰基嘌呤 烏拉坦 瘤可寧 環磷醯胺 硫唑嘌呤 馬利藍等可引起肝損害。
12,其他藥物 撲熱息痛 偶氮磺胺吡啶 聚烯吡酮碘可引起肝細胞型損害;雙硫醒 偶氮磺胺吡啶引起混合性肝細胞型損害;青黴胺 丙氧吩可引起肝細胞-毛細膽管型肝損害。
對乙醯氨基酚 保泰松 氯唑沙宗 氟哌酸 環丙沙星 羅紅黴素 酮康唑 環孢黴素A 吡嗪醯胺 非諾貝特 吉非貝齊 煙酸 洛伐他丁 甲基多巴 胺碘酮 肼苯噠嗪 卡托普利 格列本脲 西咪替丁 雷尼替丁 丙戊酸鈉 溴隱亭 甲睪酮 康力龍 尼爾雌醇 複方炔諾酮 環丙孕酮。
診斷標準
①使用某種傷肝藥物後的1—4周(少數患者的潛伏期可以更長)出現肝損傷的表現。
②除有肝炎的一般表現外,首發症狀可有發熱、皮疹、皮膚瘙癢等。
③周圍血象嗜酸粒細胞大於6%。
④有肝內膽汁淤積的表現和/或肝實質細胞損害的病理改變。
⑤各種病毒標誌物檢測陰性。
⑥再次用藥後仍可發生肝損害者。
慢性藥物性肝損傷類似於慢性肝炎。除肝臟損害外還可出現肝外表現,個別患者可發展為肝硬化,常因為損肝藥物未能及時終止或誘發機體免疫功能紊亂而導致炎症持續發展所致。因此,藥物性肝損傷應引起醫生和患者的極大重視。